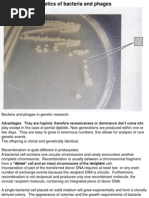

Biotechnology Timeline
8000-4000 B.C..
Humans domesticate crops
and livestock.
Potatoes first cultivated
for food.
�Biotechnology Timeline
2000 B.C.
Biotechnology used to leaven bread
and ferment beer, using yeast (Egypt).
Production of cheese, fermentation
of wine begins (Sumeria, China, Egypt).
�Biotechnology Timeline
500 B.C.
First antibiotic: Moldy soybean curds
(tofu) used to treat boils (China).
�Biotechnology Timeline
100 B.C.
First insecticide:
powdered
chrysanthemums
(China)
�Biotechnology Timeline
1797
First vaccination
Edward Jenner takes pus
from a cowpox lesion,
inserts it
into an incision
on a boy's arm.
�Biotechnology Timeline
1830-1833
1830 Proteins are discovered.
1833 First enzyme is
discovered and isolated.
Model of a 5-peptide protein.
�Biotechnology Timeline
1857
Louis Pasteur proposes
that microbes cause
fermentation. He later
conducts experiments
that support
the germ theory of disease.
�Biotechnology Timeline
1859
Charles Darwin publishes
the theory of evolution
by natural selection.
�Biotechnology Timeline
1865
Gregor Mendel discovers
the laws of inheritance by
studying flowers in his garden.
The science of genetics
begins.
�Biotechnology Timeline
1915
Phages viruses
that only infect bacteria
are discovered.
�Biotechnology Timeline
1927
Herman Muller discovers
that radiation causes
defects in chromosomes.
�Biotechnology Timeline
1928
Sir Alexander Fleming discovers
the antibiotic penicillin by chance
when he realizes that
Penicillium
mold kills
bacteria.
He shared the 1945 Nobel Prize in Medicine with Ernst Boris Chain
and Sir Howard Walter Florey.
�Biotechnology Timeline
1944
DNA is proven to carry
genetic information
by Oswald Avery,
Colin MacLeod and
Maclyn McCarty.
DNA model made out of LEGOs.
�Biotechnology Timeline
1953
James Watson
and Francis Crick describe
the double helical
structure of DNA. They shared
the 1962 Nobel Prize in
Medicine or Physiology with
Maurice Wilkins.
�Biotechnology Timeline
1955
The amino acid sequence
of insulin is discovered by
Frederick Sanger.
3D model of insulin
1982 Human insulin
produced in genetically
modified
bacteria is the first
biotech drug
approved by the
FDA.
�Biotechnology Timeline
1958
DNA is made in a test tube for the first time.
Sickle cell disease is
shown to occur due to a
change in one amino acid.
�Biotechnology Timeline
1966
The genetic code for DNA is cracked.
Three scientists shared the 1968 Nobel Prize in Physiology or
Medicine for the discovery.
Marshall Nirenberg
Robert Holley
Har Gobind Khorana
�Biotechnology Timeline
1971
The first complete synthesis of a gene occurs.
Discovery of restriction enzymes that cut and
splice genetic material very specifically occurs.
This opens the way for gene cloning.
�Biotechnology Timeline
1973
Stanley Cohen and Herbert Boyer perfect genetic
engineering techniques to cut and paste DNA
using restriction enzymes.
(1977 sees the first expression of a human gene in bacteria.)
Stanley Cohen
Herbert Boyer and a recombinant bacterium
Cohen won a Nobel Prize in 1986 for an unrelated discovery!
�Biotechnology Timeline
1975
Georges Kohler and Cesar Milstein
develop the technology to produce
monoclonal antibodies highly specific,
purified antibodies derived from only
one clone of cells that recognize
only one antigen. They shared the
1984 Nobel Prize in Physiology or
Medicine with Neils Jerne.
�Biotechnology Timeline
1981
The first transgenic animals
are produced by
transferring
genes from
other animals into mice.
The first patent for a
genetically modified organism
is granted for bacteria that can
break down crude oil.
�Biotechnology Timeline
1983
The polymerase chain reaction (PCR) technique,
which makes unlimited copies of genes and gene
fragments, is conceived.
Kary Mullis, who was born in Lenoir, N.C.,
wins the 1993 Nobel Prize in Chemistry
for the discovery. He became interested
in science as a child when he received
a chemistry set for Christmas.
�Biotechnology Timeline
1986
First recombinant vaccine is approved
for human use: hepatitis B.
First anti-cancer drug is produced
through biotech: interferon.
�Biotechnology Timeline
1987
First approval for field tests
of a genetically
modified food
plant:
virus-resistant tomatoes.
1994 Genetically modified
tomatoes are sold in the U.S.
for the first time.
�Biotechnology Timeline
1990
The Human Genome Project an international
effort to maps all of the genes in the human
genome is launched.
2002 The draft version of the human genome is
published.
Francis Collins, M.D., Ph.D.
Director, Human Genome Project
�Biotechnology Timeline
1997
Scientists report the birth of Dolly, the first animal
cloned from an adult cell.
Dolly (1996-2003) as an adult
Dolly and her surrogate mother
�Biotechnology Timeline
1998
Human embryonic stem cell lines are established.
They offer hope to many
because they may be
able to replace diseased
or dysfunctional cells.
�Biotechnology Timeline
2003
The SARS (severe acute respiratory
syndrome) virus is sequenced
three weeks after its discovery.
SARS, which began in China,
spreads quickly and
spreads fear throughout the
Far East and the world. The
last reported cases occurred
in 2004 and resulted from
laboratory-acquired infections.
�Biotechnology Timeline
2004
The first cloned
pet a kitten is
delivered to its
owner.
She is called CopyCat (or Cc for short).
�Biotechnology Timeline
2006
A recombinant vaccine
against human papillomavirus
(HPV) receives FDA approval.
The virus causes genital warts
and can cause cervical cancer.
�END!
Something to ponder on:
Are
GMOs good or bad?